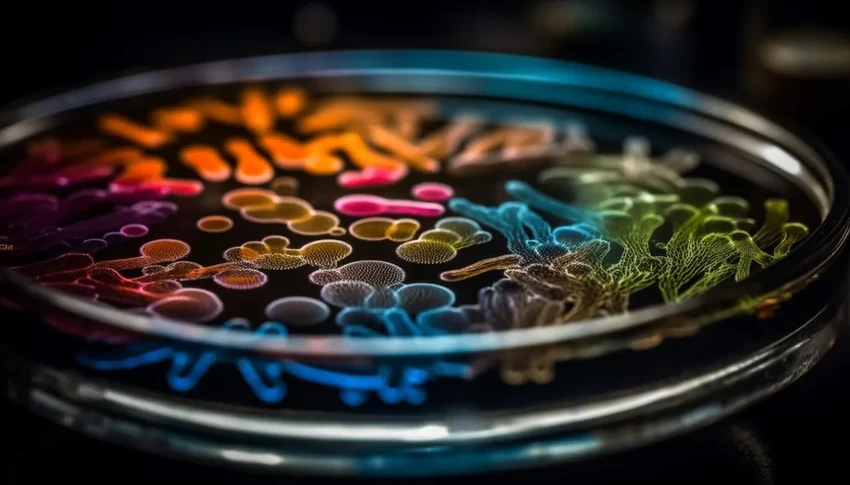
Поцелуи Брежнева и наука: как биохимия объясняет наш самый древний ритуал

Поцелуи Брежнева и наука: как биохимия объясняет наш самый древний ритуал
Зачем нам это вообще нужно? Эволюция поцелуя
Однозначного ответа нет, но ученые строят догадки. Похоже, корни уходят глубоко в нашу эволюционную историю.
«У высших приматов, наших родственников, есть прикосновения к морде — так они выражают привязанность. Вполне вероятно, что поцелуй — это наше, человеческое, развитие этого жеста», — рассуждает Юлия Неверова, социолог ПНИПУ. Получается, потребность целоваться зашита в нас на биологическом уровне?
Правда ли, что поцелуи скрепляют отношения? Гормональный взрыв
Абсолютная правда! И вот почему: во время поцелуя в мозге запускается настоящий фейерверк из нейромедиаторов и гормонов. Это не просто романтика, это сложная биохимия.
Профессор Олег Долгих объясняет, какие именно «эликсиры» вырабатываются в этот момент:
- Тестостерон — двигатель влечения. Он толкает нас на поиски партнера и придает смелости.
- Эстрадиол — поддерживает огонь страсти.
- Дофамин — наш внутренний энергетик. Он создает то самое навязчивое желание быть рядом и вызывает чувство, близкое к эйфории.
- Окситоцин — гормон доверия и привязанности. Он делает нас верными и создает чувство безопасности. Именно он шепчет нам: «Это любовь».
- Эндорфины — натуральные наркотики счастья. Их эффект в 200 раз сильнее морфия! Вот почему после хорошего поцелуя мир кажется прекрасным.

А если не целоваться? Можно ли построить отношения без этого?
«Конечно, можно, — уверяет Юлия Неверова. — Поцелуй — важная, но не единственная деталь пазла под названием «отношения». Без него доля приятного, конечно, уменьшится».
Главное — регулярно подпитывать связь. Подойдут сочувствие, искренние разговоры, комплименты и, конечно, объятия. В конце концов, окситоцин вырабатывается и от них. Но согласитесь, без поцелуев будет не то?
Как давно человечество знакомо с искусством поцелуя?
Гораздо дольше, чем мы думали! Раньше считалось, что первые свидетельства (около 3500 лет назад) пришли из Индии. Но недавние находки перевернули представления.
Ученые из Оксфорда и Копенгагена нашли записи о поцелуях, сделанные 4500 лет назад в Месопотамии и Древнем Египте. Уже тогда различали поцелуй дружеский, родительский и романтический. Любопытно, что в обществах с жесткой иерархией именно романтический поцелуй стал символом элиты.

Интересный факт: в древности поцелуй был еще и… гигиеническим тестом. Так оценивали здоровье зубов партнера. Правда, параллельно активно распространяли инфекции вроде герпеса. Плата за любопытство!
Поцелуй — это не только про любовь. Какие еще смыслы он нес?
Огромное количество! Забудьте о романтике — часто поцелуй был жестким политическим и социальным инструментом.
«Возьмем, к примеру, Средневековье. Целование руки Папы Римского с перстнем символизировало полное подчинение его воле. От этой традиции начали отходить лишь во время пандемии COVID-19», — рассказывает социолог Константин Антипьев.

В древних монархиях поцелуй монарха в определенное место (лоб, руку) был знаком высочайшей милости. Целование же ступней правителя означало мольбу о прощении.
А помните легендарные поцелуи Леонида Брежнева? Говорят, он подсмотрел этот жест у Ясира Арафата в 1968 году. Для генсека это был символ нерушимой дружбы между целыми народами. Самый известный «братский поцелуй» с Эрихом Хонеккером даже стал граффити на Берлинской стене.

Так зачем же нужна слюна? Не только для поцелуев
В момент поцелуя мы активно обмениваемся слюной. А это не просто «вода». Это сложнейший секрет, производимый сотнями желез.
«Слюна увлажняет полость рта, помогает артикуляции и восприятию вкуса. Она склеивает пищу в комок для легкого глотания, очищает зубы и защищает их от повреждений», — объясняет химик Анна Портнова.

В ней содержатся ферменты, которые уже во рту начинают расщеплять углеводы. А ее уникальная способность — нейтрализовать и кислоты, и щелочи. Кстати, диета влияет на эту функцию: избыток сладкого ее снижает, а белковая пища — усиливает, защищая от кариеса.
Из чего же, из чего же сделана наша слюна?
На 98-99% — из воды. Но оставшийся один процент — это целая вселенная! Соли, микроэлементы, бактерицидный лизоцим, ферменты, витамины группы B и муцин — вещество, формирующее тот самый пищевой комок.
«Состав слюны — не константа, — добавляет Анна Портнова. — Он меняется в зависимости от того, что мы едим. После сладкого среда становится более кислой и благоприятной для бактерий».
Какие секреты о здоровье может выдать наша слюна?
Огромные! Исследования в этой области бурно развиваются. Оказалось, что уровень многих микроэлементов в слюне тесно коррелирует с их уровнем в крови.
«В слюне можно найти гормоны, иммунные компоненты (как тот же лизоцим) и даже маркеры экологического неблагополучия региона, где живет человек, — отмечает Олег Долгих. — Анализ ДНК из слюны позволяет оценить генетическую предрасположенность к различным болезням».
Что конкретно можно узнать, сдав слюну на анализ?
Практически все! Мы ищем в биоматериале особые молекулы-маркеры.
«Это могут быть продукты метаболизма, фрагменты ДНК, специфические белки. По ним диагностируют онкологию, аутоиммунные заболевания, диабет на самых ранних стадиях, когда человек еще не чувствует симптомов», — говорит химик Ольга Красных.

Помните ПЦР-тесты на ковид? Материал брали именно со слизистой, богатой слюной. Такой анализ показывает не только наличие болезни, но и то, насколько эффективно лечение.
Можно ли диагностировать депрессию по слюне?
Да, и это одно из самых перспективных направлений! В слюне содержится мелатонин — гормон, регулирующий наши биологические часы и влияющий на настроение.

Его низкий уровень часто сопровождает депрессивные состояния. Анализ слюны может показать, эффективны ли принимаемые пациентом антидепрессанты, на генетическом уровне.
«Ученые по всему миру работают над созданием тестов по слюне для выявления маркеров рака, болезней сердца и даже уровня серотонина — «гормона счастья», — добавляет Ольга Красных.
Опасны ли поцелуи? Чем можно заразиться
Увы, риски есть. В первую очередь, это все, что передается воздушно-капельным путем: грипп, ковид, корь, паротит.
«Высока вероятность передачи герпесвирусов (мононуклеоз, цитомегаловирус), гепатита А. Реже, но возможно — вируса папилломы человека», — предупреждает биолог Лариса Нестерова.
Через поцелуй можно «поделиться» и бактериями, вызывающими кариес и гастрит. Вероятность заражения сифилисом существует при наличии язвочек во рту. Статистика проста: чем больше партнеров, тем выше риск. Но достаточно и одного больного человека.

Вывод прост: не целуйтесь с тем, у кого явные признаки ОРВИ. Здравый смысл — лучшая защита.
А как же младенцев? Целовать или нет?
С точки зрения медицины — крайне нежелательно. Иммунитет малыша только формируется. Инфекция, которая у взрослого пройдет незаметно, для младенца может стать серьезной угрозой.

Особенно опасны поцелуи в губы, глаза и нос — самые уязвимые слизистые оболочки. Проявите любовь иначе — объятиями и нежными прикосновениями.
А животные? Они целуются?
В своем роде — да! Для человеческого поцелуя нужны подвижные губы, как у человекообразных обезьян. Другие виды вылизывают или покусывают партнера в рамках ухаживания.
Птицы и земноводные трутся клювами или мордами, выражая симпатию. Так что медведи, слоны и даже черепахи — все они в какой-то мере знают толк в нежных прикосновениях.

Кто безопаснее: человек или домашний любимец?
Сложный вопрос. Домашние животные могут быть переносчиками болезней (вирусов, грибков, бактерий, гельминтов), опасных и для человека. Риск минимален, если питомец домашний, вакцинирован и питается проверенным кормом.
Но если кошка или собака гуляют на улице, едят сырое мясо или рыбу — вероятность подхватить и передать вам какую-нибудь заразу возрастает. Бактерии можно принести и на собственной обуви.

Так что, целуя пушистого друга, вы целуете, по сути, все, с чем он контактировал. Звучит не очень романтично, правда? Может, ограничиться поглаживаниями?










